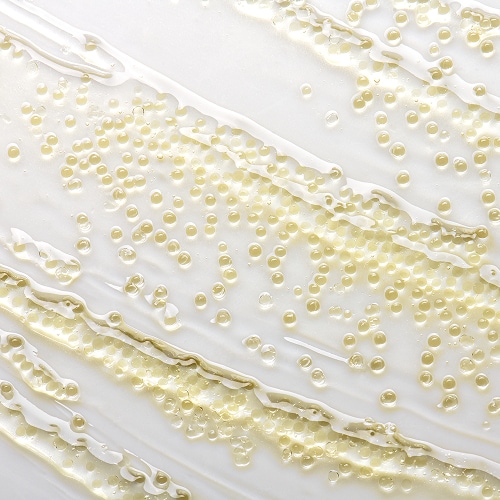

95% of the formula contains natural ingredients*
*Per the ISO standard 16128, from plant sources, non-petroleum mineral sources, and/or water
Non-comedogenic.
INGREDIENTS: WATER\AQUA\EAU [] PROPANEDIOL [] CAPRYLIC/CAPRIC TRIGLYCERIDE [] GLYCERIN [] LIMNANTHES ALBA (MEADOWFOAM) SEED OIL [] BETAINE [] PENTYLENE GLYCOL [] COCO-CAPRYLATE/CAPRATE [] SESAMUM INDICUM (SESAME) SEED OIL [] BUTYLENE GLYCOL [] MOLASSES EXTRACT\SACCHARUM OFFICINARUM\EXTRAIT DE MELASSE [] SIGESBECKIA ORIENTALIS (ST. PAUL'S WORT) EXTRACT [] OLEA EUROPAEA (OLIVE) FRUIT OIL [] HELANTHUS ANNUUS (SUNFLOWER) SEED OIL [] CUCURBITA PEPO (PUMPKIN) SEED EXTRACT [] HYDROLYZED RICE EXTRACT [] LAMINARIA DIGITATA EXTRACT [] LAMINARIA SACCHARINA EXTRACT [] MYRTUS COMMUNIS LEAF EXTRACT [] OLEA EUROPAEA (OLIVE) LEAF EXTRACT [] IRIS FLORENTINA ROOT EXTRACT [] COFFEA ARABICA (COFFEE) SEED EXTRACT [] CENTELLA ASIATICA (HYDROCOTYL) EXTRACT [] TOCOPHEROL [] SACCHAROMYCES LYSATE EXTRACT [] PASSIFLORA INCARNATA FLOWER EXTRACT [] ACETYL HEXAPEPTIDE-8 [] LYTHRUM SALICARIA EXTRACT [] LEONTOPODIUM ALPINUM EXTRACT [] NARCISSUS TAZETTA BULB EXTRACT [] SIMMONDSIA CHINENSIS (JOJOBA) SEED OIL [] LITHOSPERMUM ERYTHRORHIZON ROOT EXTRACT [] ROSMARINUS OFFICINALIS (ROSEMARY) LEAF EXTRACT [] ETHYLHEXYLGLYCERIN [] TREHALOSE [] CAPRYLYL GLYCOL [] CAFFEINE [] SODIUM HYALURONATE [] HYDROLYZED YEAST PROTEIN [] 1,2-HEXANEDIOL [] CASTOR OIL/IPDI COPOLYMER [] CARBOMER [] SODIUM HYDROXIDE [] TRISODIUM ETHYLENEDIAMINE DISUCCINATE [] CITRIC ACID [] LINALOOL [] FRAGRANCE (PARFUM) [] BENZYL SALICYLATE [] LIMONENE [] HEXYL CINNAMAL [] TOCOPHERYL ACETATE [] BHT [] PHENOXYETHANOL [] POTASSIUM SORBATE [] SODIUM BENZOATE [] CHLORPHENESIN [] VIOLET 2 (CI 60725) [] GREEN 6 (CI 61565) >ILN51028>
Please be aware that ingredient lists may change or vary from time to time. Please refer to the ingredient list on the product package you receive for the most up to date list of ingredients.
![{{ prod_PROD_RGN_NAME }} {{ prod_PROD_RGN_NAME }}]() {{/ prod_IMAGE_S }}
{{/ prod_IMAGE_S }}